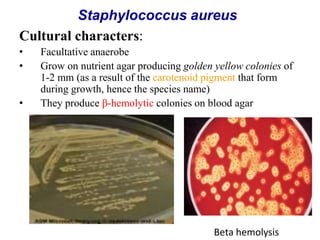
Cultural characters:
• Facultative anaerobe
• Grow on nutrient agar producing golden yellow colonies of
1-2 mm (as a result of the carotenoid pigment that form
during growth, hence the species name)
• They produce β-hemolytic colonies on blood agar
Beta hemolysis
Staphylococcus aureus

The document provides a schedule for microbiology lectures and practical classes on skin and soft tissue infections held at Addis Ababa University from January 28 to February 10, 2015. The schedule details 13 hours of lectures on topics including streptococcal infections, staphylococcal infections, leprosy, viral exantems, gas gangrene, and cutaneous fungal infections. Corresponding practical classes are also listed covering bacterial culture techniques and identification. References for further reading are provided at the end.